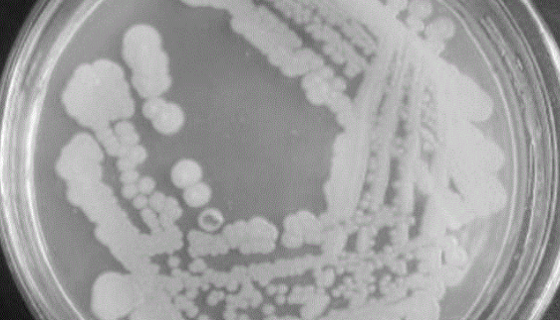
苍白杆菌属——用于抗细菌和乳品蛋白变性

猪骨骼肌卫星细胞永生化的运输和保存以及培养!
猪骨骼肌卫星细胞永生化的运输和保存及处理方法与培养步骤!

DSM 3318 马泽氏甲烷八叠球菌 百欧博伟生物
马泽氏甲烷八叠球菌是Methanosarcina属的微生物,...

NB2-11大鼠淋巴瘤细胞的质量检测与培养方式!
大鼠淋巴瘤细胞的质量检测与培养方式及注意事项有哪些?

GH3(大鼠垂体瘤细胞)性质、用途与生产工艺!
大鼠垂体瘤细胞源自大鼠垂体瘤,分泌泌乳素;表达功能性多巴胺受...

小鼠皮下结缔组织细胞的处理方法与培养步骤!
小鼠皮下结缔组织细胞收到后的处理方法与培养步骤及注意事项有哪...

ATCC 6419 柑橘生疫霉知识解析与形态描述!
柑橘生疫霉属于生物细菌,主要用于研生产,研究。

小鼠逆转录病毒包装株的处理方法与培养步骤!
小鼠逆转录病毒包装株收到后的处理方法与培养步骤及注意事项有哪...

DSM 18531 沼泽甲烷杆菌 百欧博伟生物
甲烷杆菌是一种在厌氧条件下以甲烷为特异代谢产物的细菌。其代谢...
苍白杆菌属——用于抗细菌和乳品蛋白变性
苍白杆菌属菌种是Ochrobactrum属的微生物,原产地为...